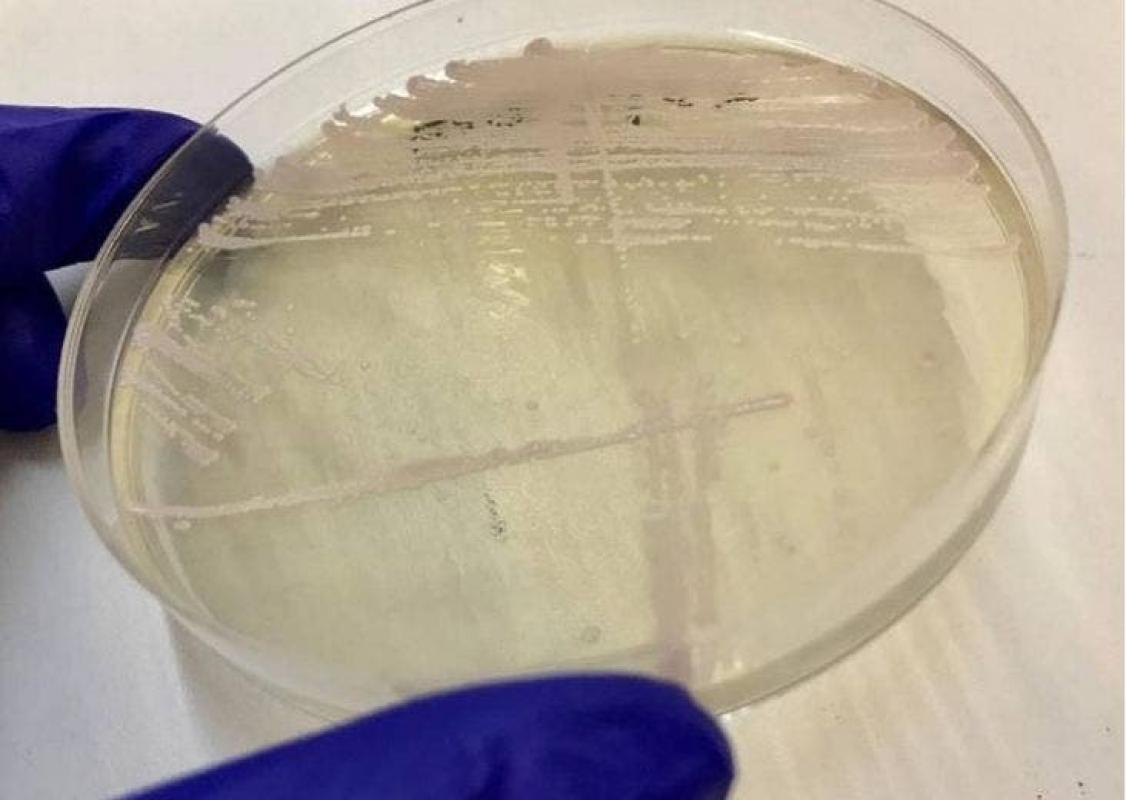

Reportan primer caso en Chile de Candida Auris, el peligroso hongo resistente a tratamientos
Reportan primer caso en Chile de Candida Auris, el peligroso hongo resistente a tratamientos
Reportan primer caso en Chile de Candida Auris, el peligroso hongo resistente a tratamientos
T13 En Vivo
Microbiólogas e Infectólogos del Hospital del Salvador en Santiago, reportaron el primer caso en Chile de Candida Auris en un paciente diabético tipo II, que tuvo signos de isquemia y necrosis en un pie.
Según un documento elaborado por la Sociedad Chilena de Infectología, la detección de este hongo se realizó en diciembre de 2018 luego de tomar una muestra al tejido de su pierna tras ser amputado parte de su pie.
La cepa tomada en la muestra fue enviada por el personal médico al Instituto de Salud Pública (ISP), quién confirmó la detección de Candida Auris en el paciente.
El hongo Candida Auris es considerado "una seria amenaza para salud pública", según el informe por tres razones:
- La resistencia que presenta a múltiples antifúngicos comúnmente utilizados para tratar las infecciones por Candida.
- Error en la identificación con los métodos de laboratorio estándar.
- Ser causa de brotes intrahospitalarios en los cinco continentes.
Por lo anterior, la Sociedad Chilena de Infectología informó que "es importante identificar rápidamente la presencia de C. auris en un paciente hospitalizado, para que se puedan tomar las precauciones especiales para detener su propagación".
Además, hicieron un llamado a los especialistas de la salud a seguir las recomendaciones del Centro de Prevención y Control de enfermedades para evitar su propagación, pues es un hongo altamente contagioso y de fácil transmisión.







